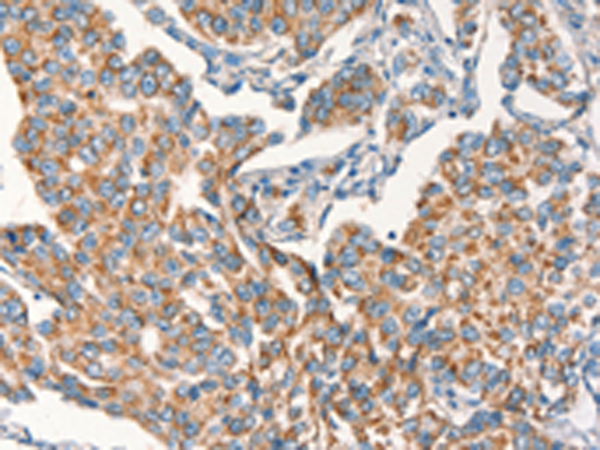
一抗

|
Background: |
Desmosomes are intercellular junctions that tightly link adjacent cells. Desmoplakin is an obligate component of functional desmosomes that anchors intermediate filaments to desmosomal plaques. The N-terminus of desmoplakin is required for localization to the desmosome and interacts with the N-terminal region of plakophilin 1 and plakoglobin. The C-terminus of desmoplakin binds with intermediate filaments. In the mid-region of desmoplakin, a coiled-coiled rod domain is responsible for homodimerization. Mutations in this gene are the cause of several cardiomyopathies and keratodermas as well as the autoimmune disease paraneoplastic pemphigus. |
|
Applications: |
ELISA, IHC |
|
Name of antibody: |
DSP |
|
Immunogen: |
Synthetic peptide of human DSP |
|
Full name: |
desmoplakin |
|
Synonyms: |
DP; DPI; DPII |
|
SwissProt: |
P15924 |
|
ELISA Recommended dilution: |
1000-2000 |
|
IHC positive control: |
Human breast cancer and Human brain |
|
IHC Recommend dilution: |
25-100 |

 購物車
購物車 幫助
幫助
 021-54845833/15800441009
021-54845833/15800441009